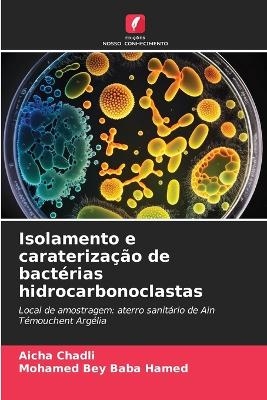
Isolamento e caraterização de bactérias hidrocarbonoclastas

Buch | Softcover
2023
|
Edizioni Sapienza
ISBN: 9786206685029
CHF 59,80 (inkl. MwSt)
- Keine Verlagsinformationen verfü
gbar